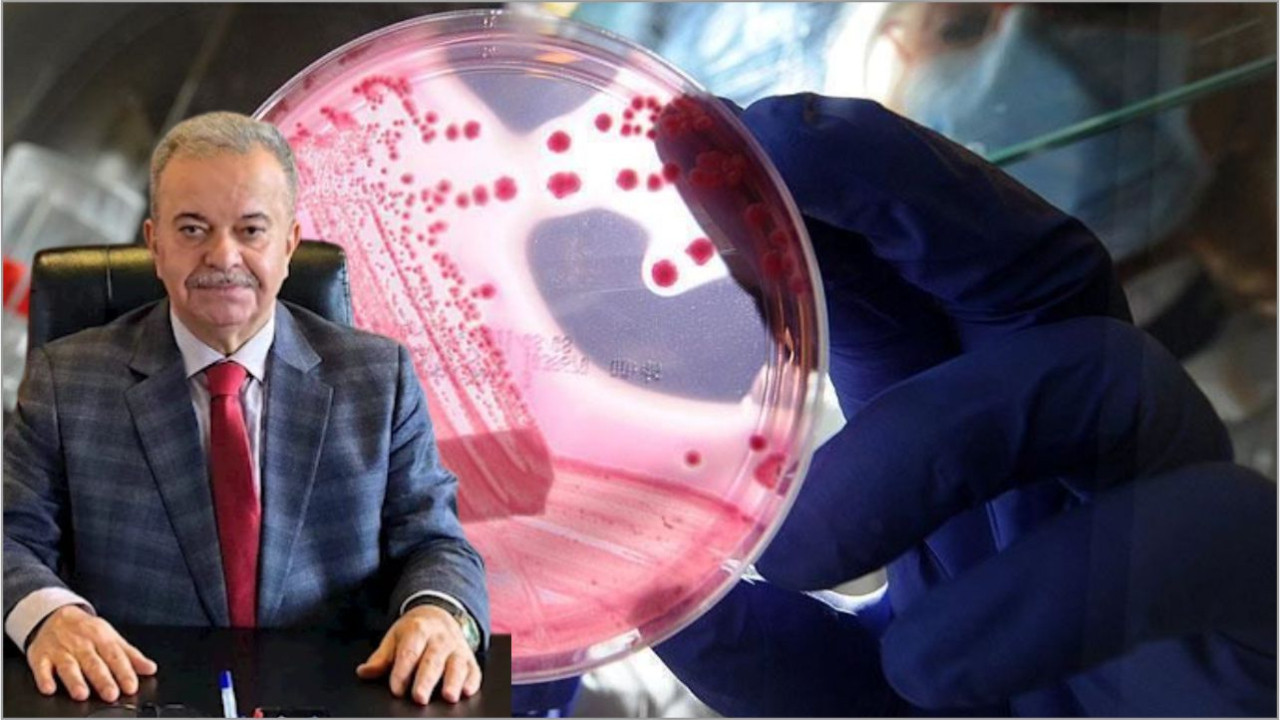

Balıkesir Devlet Hastanesi Başhekimi Ünal'dan Önemli Uyarı!
Balıkesir Devlet Hastanesi Başhekimi Op. Dr. Erdal Ünal’dan Meme Kanseri Farkındalık Ayı’nda Uyarı:
“Erken Tanı Hayat Kurtarır”
Balıkesir Devlet Hastanesi Başhekimi ve Genel Cerrahi Uzmanı Op. Dr. Erdal Ünal, 01-31 Ekim Meme Kanseri Farkındalık Ayı kapsamında yaptığı açıklamada, meme kanserinde erken teşhisin hayat kurtardığını vurguladı.

Dr. Ünal, meme kanserinin kadınlarda en sık görülen kanser türü olduğunu belirterek, erken tanı sayesinde hastalığın tamamen tedavi edilebileceğini söyledi. Kadınların hiçbir şikayetleri olmasa bile düzenli kontrollerini ihmal etmemeleri gerektiğini ifade eden Ünal,
“40-69 yaş arasındaki kadınların 2 yılda bir mamografi çektirmesi büyük önem taşıyor.”
dedi.

“Mamografi, zararsız ve en etkili tanı yöntemi”
Mamografi cihazlarının, henüz elle hissedilemeyen tümörleri tespit edebilen dijital teknolojiye sahip olduğunu belirten Dr. Ünal, bu cihazların güvenli ve zararsız olduğunu vurguladı.
Erken teşhisin tedavi sürecinde başarıyı artırdığını söyleyen Ünal, Balıkesir’deki tüm kadınları kontrollerini yaptırmaya çağırdı.
“Ücretsiz tarama hizmetlerinden yararlanın”
Dr. Ünal, 40-69 yaş arası kadınların Kanser Erken Teşhis, Tarama ve Eğitim Merkezleri (KETEM), Sağlıklı Hayat Merkezleri ve Aile Sağlığı Merkezleri üzerinden ücretsiz tarama hizmeti alabildiğini hatırlattı.
“Sevdikleriniz için kontrollerinizi yaptırın”
Açıklamasının sonunda Dr. Ünal, şu mesajı paylaştı:
“Unutmayalım, erken tanı hayat kurtarır. Kendinizi ihmal etmeyin, sevdikleriniz için kontrollerinizi yaptırın.”
 ChatGPT "Sorun yok" Dedi, Ölmek Üzere Olduğu Ortaya Çıktı!Teknoloji
ChatGPT "Sorun yok" Dedi, Ölmek Üzere Olduğu Ortaya Çıktı!Teknoloji Balıkesir'de Müsilaj Görüldü! Müdürlük Harekete GeçtiBalıkesir Son Dakika Haberleri
Balıkesir'de Müsilaj Görüldü! Müdürlük Harekete GeçtiBalıkesir Son Dakika Haberleri



